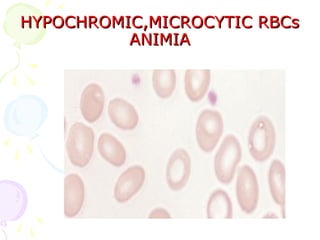
HYPOCHROMIC,MICROCYTIC RBCs
          ANIMIA
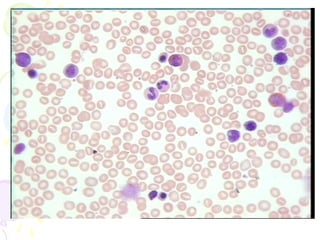

1. Plasma is the liquid component of blood in which formed elements such as cells and platelets are suspended. It makes up 55% of total blood volume.
2. When blood is centrifuged, it separates into distinct layers - the bottom layer contains erythrocytes, the thin middle layer contains leukocytes and platelets, and the remaining clear fluid is plasma.
3. The main functions of red blood cells include transport of oxygen, carbon dioxide, and hormones throughout the body. White blood cells and platelets are involved in defense against infection and clotting at the site of injury.